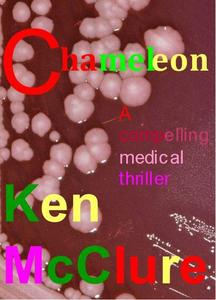

|
Название книги: Chac Mool Авторы: Фуэнтес Карлос Жанры: prose_classic Файл: fb2-091841-104214.zip/99964.fb2 Размер файла: 136,0 КБ Язык: Испанский |
Читать онлайн |
| Скачать: | ||
| fb2 | ||
| fb2+zip | ||
| epub | ||
| mobi | ||
|
En este breve ensayo-reseña se pretenderá distinguir el leitmotiv dentro de su cuento Chac Mool: las reminiscencias prehispánicas y el pasado indígena, pulsiones constantes en el trabajo del escritor. Conscientes estamos que intentar aprehender las fuentes del discurso literario de Fuentes es una tarea titánica, ya que independientemente de la vastedad de su obra y de la densidad de sus historias, determinar las ideas o mociones de un autor tan prolífico es adentrarse dentro de un maremágnum que no admite clasificación. Por tal razón sólo me atreveré a esbozar ideas y sugerir motivos. Impulsos esenciales e innegables que nos permiten comprender el mundo representando y ficticio del autor. Fuentes no olvida, o al menos pretende no hacerlo, construye amalgamas que nos intuyen y justifican. Pensemos en el difuminado y nebuloso personaje Ixca Cienfuegos de La región más transparente, o en el Cristóbal Nonato, o en el misticismo de Aura o en La muerte de Artemio Cruz. En todos lados el escritor recurre a su herencia, aunque francamente en algunas ocasiones sus radiografías sociales parezcan más una especie de turismo sociológico o análisis de vitrina (Agua Quemada, Los años con Laura Díaz, Cambio de piel y La misma Región…). Sin embargo, la calidad de sus obras como su alta cota literaria es indiscutible, considero que tanto Cantar de ciegos como Los días enmascarados son libros excelentes. Sobre este último, o mejor dicho, sobre el cuento del Chac Mool, versa este opúsculo |
||

|
Название книги: Chaga Авторы: Макдональд Йен Жанры: sf Файл: fb2-458900-463399.zip/460015.fb2 Размер файла: 1,1 МБ Язык: Английский |
Читать онлайн |
| Скачать: | ||
| fb2 | ||
| fb2+zip | ||
| epub | ||
| mobi | ||
|
A fantasy adventure following network journalist Gaby McAslan to Africa to research the Kilimanjaro Event – a meteor which landed in Kenya causing the African landscape to give way to the “Chaga”, an alien flora able to destroy all man-made materials and mould human flesh, bone and spirit |
||

|
Название книги: Chagrin d'école Авторы: Пеннак Даниэль Жанры: prose_contemporary Файл: fb2-593000-596999.zip/596935.fb2 Размер файла: 443,3 КБ Язык: Французский |
Читать онлайн |
| Скачать: | ||
| fb2 | ||
| fb2+zip | ||
| epub | ||
| mobi | ||
|
Chagrin d’école, dans la lignée de Comme un roman, aborde la question de l’école du point de vue de l’élève, et en l’occurrence du mauvais élève. Daniel Pennac, ancien cancre lui-même, étudie cette figure du folklore populaire en lui donnant ses lettres de noblesse, en lui restituant aussi son poids d’angoisse et de douleur |
||

|
Название книги: Chain of Bargains Авторы: Inlo Jeff Жанры: sf_fantasy Серии: Delver magic No в серии:5 Файл: fb2-426000-433000.zip/429838.fb2 Размер файла: 963,5 КБ Язык: Английский |
Читать онлайн |
| Скачать: | ||
| fb2 | ||
| fb2+zip | ||
| epub | ||
| mobi | ||

|
Название книги: Chain of Evidence Авторы: Дишер Гарри Жанры: det_police Серии: Inspector Challis No в серии:4 Файл: fb2-406000-410999.zip/409723.fb2 Размер файла: 642,7 КБ Язык: Английский |
Читать онлайн |
| Скачать: | ||
| fb2 | ||
| fb2+zip | ||
| epub | ||
| mobi | ||

|
Название книги: Chain of Evidence Авторы: Пирсон Ридли Жанры: thriller Файл: fb2-400000-405999.zip/404959.fb2 Размер файла: 682,6 КБ Язык: Английский |
Читать онлайн |
| Скачать: | ||
| fb2 | ||
| fb2+zip | ||
| epub | ||
| mobi | ||

|
Название книги: Chain of Fools Авторы: Стивенсон Ричард Жанры: det_crime Серии: Donald Strachey No в серии:6 Файл: fb2-375000-381999.zip/378671.fb2 Размер файла: 358,5 КБ Язык: Английский |
Читать онлайн |
| Скачать: | ||
| fb2 | ||
| fb2+zip | ||
| epub | ||
| mobi | ||

|
Название книги: Chain of Illusions Авторы: Brux Boone Жанры: love_sf Серии: Bringer and the Bane No в серии:3 Файл: fb2-472000-475999.zip/472348.fb2 Размер файла: 724,1 КБ Язык: Английский |
Читать онлайн |
| Скачать: | ||
| fb2 | ||
| fb2+zip | ||
| epub | ||
| mobi | ||
|
Rell has lived in the Shadow World for thirteen years as a Demon Bane, the formerly vivacious young woman now the demonic enemy of the immortal Bringers. But when she is given the chance to become human again—and a full-powered Bringer—Rell isn’t sure if it’s better to be a demon in the Shadow World or to risk her life for her humanity. For two years Siban had been tortured in the Bane prison, only to fall in love with the beautiful demon who helped him escape. Tormented by the thought of never seeing her again, he maintains a life of solitude. So, when Rell’s human body is rescued from the Shadow World, he will do anything to be with her—even if it means challenging death to become a Bringer too. But once their Bringer transformations and training are completed, Siban and Rell must join a mission to go deep in the Shadow World to rescue others trapped by the Demon Bane King. And what they discover destroys everything they knew about the Demon Bane. The lovers must learn to trust themselves, each other, and their new powers if they’re going to make it out alive |
||

|
Название книги: Chain of Jedrah Авторы: Campbell Frank E Жанры: home_sex Файл: fb2-485000-489999.zip/487498.fb2 Размер файла: 369,1 КБ Язык: Английский |
Читать онлайн |
| Скачать: | ||
| fb2 | ||
| fb2+zip | ||
| epub | ||
| mobi | ||
|
A hi-jacked plane forced aground in the desert land of Jedrah. Four girls trudging over the sand dunes in a lonely search for something they do not find. This is the beginning of F.E. Campbell’s latest story of a maiden enslaved by the anger of a ruthless man and by her own destiny. It is a story of vengeance and of power through which the courage of the girl called Stacie carries her through punishment and bondage, the wearing of her slave girl chains, and the scarlet striations of the whip, into the discovery of a world of vivid passion and lustful cruelty from which she emerges virtuous in her mind, but wearing forever the marks of Jedrah upon her flesh and within her heart |
||

|
Название книги: Chain Reaction Авторы: Арчер Зоэ Жанры: love_history, love_sf Серии: 8th Wing No в серии:2 Файл: fb2-467300-471999.zip/467343.fb2 Размер файла: 450,1 КБ Язык: Английский |
Читать онлайн |
| Скачать: | ||
| fb2 | ||
| fb2+zip | ||
| epub | ||
| mobi | ||
|
Elite 8th Wing pilot Celene Jur was taken captive after a mysterious device temporarily disabled her ship's controls. Three solar months later, when Celene receives intel on the man who built the device, she's ready to get the bastard. Only problem is, the higher-ups think her mission partner should be Nils Calder, a tech-head who can understand the disabling device. The attraction between them is electric, but Celene needs a soldier who can watch her back as she exacts her revenge. Nils knows his department is nicknamed NerdWorks. Pilots like Celene think the closest tech geeks come to combat is all-night Nifalian chess tournaments. But behind the NerdWorks insignia on his sleeve Nils is an able fighter, ready to prove himself and gain Celene's trust. The desire between them is unexpected, but with the fate of thousands hanging in the balance, the hotshot pilot and the tech genius must succeed in their mission—no matter the cost |
||

|
Название книги: Chained cheerleader Авторы: Vickers Robert Жанры: home_sex Серии: bc No в серии:2016 Файл: fb2-242000-251999.zip/242582.fb2 Размер файла: 219,1 КБ Язык: Английский |
Читать онлайн |
| Скачать: | ||
| fb2 | ||
| fb2+zip | ||
| epub | ||
| mobi | ||

|
Название книги: Chained daughter Авторы: Howard Randy Жанры: home_sex Серии: bc No в серии:1026 Файл: fb2-242000-251999.zip/242590.fb2 Размер файла: 208,3 КБ Язык: Английский |
Читать онлайн |
| Скачать: | ||
| fb2 | ||
| fb2+zip | ||
| epub | ||
| mobi | ||

|
Название книги: Chained Reaction Авторы: Сэпир Ричард , Мерфи Уоррен Жанры: sf_detective Серии: The Destroyer No в серии:34 Файл: fb2-216642-221999.zip/219922.fb2 Размер файла: 306,0 КБ Язык: Английский |
Читать онлайн |
| Скачать: | ||
| fb2 | ||
| fb2+zip | ||
| epub | ||
| mobi | ||
|
Black is not only beautiful, it's Ruby Gonzalez . . . the wild CIA lady with a sure cure for what ails Remo and Chiun. Remo Williams just can't seem to forget he was once a Newark cop. But when you're the Destroyer you do need a little humility. Yellow, the worth of gold, the texture of parchment, the color of the sun source itself . . . and, in the inscrutable, insuperable, Chiun, a veritable galaxy of wisdom and power. And fun at a riot. It will be all over when Southern idiots with whips and chains, and Northern madmen with money attempt to reduce business costs by raising slavery to new levels of efficiency. The Destroyer, with a little help from his two friends, proves that billions of dollars and armies of thugs just aren't enough. Then bucks and Ruby will do |
||

|
Название книги: Chained slave wife Авторы: Silvers Nathan Жанры: home_sex Серии: Bondage House No в серии:8200 Файл: fb2-262000-274999.zip/267431.fb2 Размер файла: 386,1 КБ Язык: Английский |
Читать онлайн |
| Скачать: | ||
| fb2 | ||
| fb2+zip | ||
| epub | ||
| mobi | ||

|
Название книги: Chained To Desire Авторы: Herty Andrea Жанры: home_sex Серии: Beeline Double novel No в серии:61721 Файл: fb2-565000-568999.zip/565883.fb2 Размер файла: 521,4 КБ Язык: Английский |
Читать онлайн |
| Скачать: | ||
| fb2 | ||
| fb2+zip | ||
| epub | ||
| mobi | ||

|
Название книги: Chained trained wife Авторы: Bonds Jason Жанры: home_sex Серии: Bondage House No в серии:8248 Файл: fb2-262000-274999.zip/269043.fb2 Размер файла: 397,7 КБ Язык: Английский |
Читать онлайн |
| Скачать: | ||
| fb2 | ||
| fb2+zip | ||
| epub | ||
| mobi | ||

|
Название книги: Chained wife Авторы: Watson J T Жанры: home_sex Серии: Bondage House No в серии:8141 Файл: fb2-262000-274999.zip/265111.fb2 Размер файла: 260,1 КБ Язык: Английский |
Читать онлайн |
| Скачать: | ||
| fb2 | ||
| fb2+zip | ||
| epub | ||
| mobi | ||

|
Название книги: Chained women Авторы: Watson J T Жанры: home_sex Серии: Bondage House No в серии:8010 Файл: fb2-252000-261999.zip/260754.fb2 Размер файла: 336,8 КБ Язык: Английский |
Читать онлайн |
| Скачать: | ||
| fb2 | ||
| fb2+zip | ||
| epub | ||
| mobi | ||

|
Название книги: Chained, whipped librarians Авторы: Friday John Жанры: home_sex Серии: Bondage House No в серии:8197 Файл: fb2-262000-274999.zip/267427.fb2 Размер файла: 278,0 КБ Язык: Английский |
Читать онлайн |
| Скачать: | ||
| fb2 | ||
| fb2+zip | ||
| epub | ||
| mobi | ||

|
Название книги: Chainers Torment Авторы: Макгоу Скотт Жанры: sf_fantasy Серии: Odyssey Cycle No в серии:2 Файл: fb2-212752-216641.zip/213632.fb2 Размер файла: 524,4 КБ Язык: Английский |
Читать онлайн |
| Скачать: | ||
| fb2 | ||
| fb2+zip | ||
| epub | ||
| mobi | ||

|
Название книги: Chainfire Авторы: Гудкайнд Терри Жанры: sf_fantasy Серии: The Sword of Truth No в серии:9 Файл: fb2-449400-453299.zip/452310.fb2 Размер файла: 1,6 МБ Язык: Английский |
Читать онлайн |
| Скачать: | ||
| fb2 | ||
| fb2+zip | ||
| epub | ||
| mobi | ||
|
With Wizard’s First Rule and seven subsequent masterpieces, Terry Goodkind has thrilled readers worldwide with the unique sweep of his storytelling. Now Goodkind returns with a new novel of Richard and Kahlan, the beginning of a sequence of three novels that will bring their epic story to its culmination. After being gravely injured in battle, Richard awakes to discover Kahlan missing. To his disbelief, no one remembers the woman he is frantically trying to find. Worse, no one believes that she really exists, or that he was ever married. Alone as never before, he must find the woman he loves more than life itself . . . if she is even still alive. If she was ever even real |
||

|
Название книги: Chaining the Lady Авторы: Энтони Пирс Жанры: sf_space Серии: Cluster No в серии:2 Файл: fb2-230000-241999.zip/232149.fb2 Размер файла: 735,4 КБ Язык: Английский |
Читать онлайн |
| Скачать: | ||
| fb2 | ||
| fb2+zip | ||
| epub | ||
| mobi | ||
|
CHAINING THE LADY is the second CLUSTER book. Melody, a product of Flint and the Andromedan’s mating in CLUSTER, must save the Milky Way Galaxy and create a place where creatures can transfer without limitations. Melody must survive in worlds unknown and alien to her and she does that where others fail when her aura augments her skills and abilities. The book opens with the discovery that Andromeda, the enemy galaxy of the first novel, has discovered the secret of involuntary hosting: a Kirlian aura that is sufficiently stronger than that of an individual can take possession of that individual. Andromeda has secretly infiltrated the highest levels of government in Sphere Sol and its allies and resurrect its plot to steal the energy of the Milky Way. Melody of Mintaka, a direct descendant of Flint of Outworld and his Andromedan nemesis, has a Kirlian aura of well over 200. She is pressed into service to “possess” and interrogate a captured Andromedan transferee. Melody, hosted in the young and beautiful body of Yael of Dragon, must, like her progenitor Flint, find a way to defeat the Andromedan threat and save the galaxy. The mysterious Ancients are present again in the form of their artifacts and sites. The themes of Tarot and of various myths of Sphere Sol (in this case that of Perseus and Andromeda) play a big part this novel. The interSphere fleet of starships has forms analogous to the Tarot suits of Disks, Cups, Wands and Swords |
||

|
Название книги: Chains for Linda Авторы: Boyer Brad Жанры: home_sex Серии: bondage book No в серии:215 Файл: fb2-242000-251999.zip/251884.fb2 Размер файла: 323,7 КБ Язык: Английский |
Читать онлайн |
| Скачать: | ||
| fb2 | ||
| fb2+zip | ||
| epub | ||
| mobi | ||

|
Название книги: Chains of Darkness Авторы: Roane Caris Жанры: love_sf Серии: Men in Chains No в серии:2 Файл: fb2-506000-511999.zip/506499.fb2 Размер файла: 552,0 КБ Язык: Английский |
Читать онлайн |
| Скачать: | ||
| fb2 | ||
| fb2+zip | ||
| epub | ||
| mobi | ||
|
Lucian has woken up bound in chains in a place he doesn't recognize. Weak from being tortured, beaten and cut to ribbons by a whip, he's filled with anger and confusion. Why is he here? What do his captors want from him? And just how much does his situation have to do with the beautiful woman in front of him? Claire doesn't agree with the way her group has treated Lucian...even though he's a vampire. Torn by her own conscience, she asks one critical question: will he chain himself to her for his freedom? Her intention is to keep an eye on him, prevent him from harming anyone, and use him in her quest to stop the vampire race from their bloodthirsty acts of destruction. But Claire didn't expect Lucian's seductive power, and before she knows it, her captive has captured her own heart and soul |
||

|
Название книги: Chains of Frost Авторы: Грей Т. А. Жанры: love_erotica, love_sf Серии: The Bellum Sisters No в серии:1 Файл: fb2-495000-500999.zip/495094.fb2 Размер файла: 536,0 КБ Язык: Английский |
Читать онлайн |
| Скачать: | ||
| fb2 | ||
| fb2+zip | ||
| epub | ||
| mobi | ||
|
Three Fates. Three Sisters. When a will from her dead father decrees Chloe into the protection of the renowned vampire commander, Tyrian en Kulev, she does what any woman would do—and casts a spell. Things get worse for Chloe when the spell she and her sisters perform summons an ancient demon from deep within the earth. Now she's being hunted by a demon set on killing her and must live at the aptly named Castle Death with the king of cold, Tyrian. Surprisingly, Chloe finds that she doesn’t mind her new Protector so much. His cold, impassionate nature needs a firm push to show his true colors, and Chloe thinks she’s just the one to do it. Tyrian en Kulev always pays his debts. When Francis Bellum dies and orders Tyrian to act as his eldest daughter’s Protector, Tyrian resigns himself to the position. What should have been a simple deal--keep her in the castle, protect her--has turned difficult. Chloe comes to him with a demon trying to kill her and a sexy attitude that keeps invading his thoughts everywhere he goes. The little succubus easily grabs hold of the heart he’d kept locked away for so long and makes him feel once again. But can they defeat the demon that haunts her and can Tyrian overcome his past and move on to a new future with Chloe? Chains of Frost is a full-length novel |
||

|
Название книги: Chairman Mao Would Not Be Amused Авторы: Ван Мэн , Сюэ Цань , Дуо Дуо , Бэй Ай , Найцянь Цао , Ли Чи , Цунь Чэнь , Фэй Гэ , Ин Хун , Кун Цзешэн , Жуй Ли , Сяо Ли , Янь Мо , Ши Тяньшэн , Сянфу Ван , Чжэнгуан Ян , Хуа Юй , Тун Су , Ран Чен , Фэйюй Би Жанры: prose_contemporary Файл: fb2-175952-182284.zip/177026.fb2 Размер файла: 684,5 КБ Язык: Английский |
Читать онлайн |
| Скачать: | ||
| fb2 | ||
| fb2+zip | ||
| epub | ||
| mobi | ||
|
From Publishers Weekly In contrast to the utopian official literature of Communist China, the stories in this wide-ranging collection marshal wry humor, entangled sex, urban alienation, nasty village politics and frequent violence. Translated ably enough to keep up with the colloquial tone, most tales are told with straightforward familiarity, drawing readers into small communities and personal histories that are anything but heroic. "The Brothers Shu," by Su Tong (Raise the Red Lantern), is an urban tale of young lust and sibling rivalry in a sordid neighborhood around the ironically named Fragrant Cedar Street. That story's earthiness is matched by Wang Xiangfu's folksy "Fritter Hollow Chronicles," about peasants' vendettas and local politics, and by "The Cure," by Mo Yan (Red Sorghum; The Garlic Ballads), which details the fringe benefits of an execution. Personal alienation and disaffection are as likely to appear in stories with rural settings (Li Rui's "Sham Marriage") as they are to poison the lives of urban characters (Chen Cun's "Footsteps on the Roof"). Comedy takes an elegant and elaborate form in "A String of Choices," Wang Meng's tale of a toothache cure, and it assumes the burlesque of small-town propaganda fodder in Li Xiao's "Grass on the Rooftop." Editor Goldblatt has chosen not to expand the contributors' biographies or elaborate on the collection's post-Tiananmen context. He lets the stories speak for themselves, which, fortunately, they do, quietly and effectively. From Library Journal The 20 authors represented here range from Wang Meng, the former minister of culture, to Su Tong, whose Raise the Red Lantern has been immortalized on screen. *** Chinese literature has changed drastically in the past thirty years. During the Cultural Revolution (1966-1976) arts and literature of all sorts were virtually nonexistent since they were frowned upon by official powers so that attempts to produce any were apt to cause one’s public humiliation and possibly even death by the Red Guards and other unofficial arms of the government. After 1976, in the wake of Mao’s death, literature slowly regained its importance in China, and by the mid-1980s dark, angry, satirical writings had become quite prominent on the mainland. In the wake of Tiananmen Square, dark literature faded somewhat, but never vanished. Now Howard Goldblatt, a prominent translator of Chinese fiction and editor of the critical magazine Modern Chinese Literature, has compiled a representative collection of contemporary Chinese fiction entitled Chairman Mao Would Not Be Amused. Even with my limited knowledge of modern China I feel certain the title of the book is fairly accurate. Mo Yan is one of my favorite contemporary writers. His dark, no-holds-barred satires Red Sorghum and The Garlic Ballads detailed what he sees as the failings of both Chinese peasants (of which he was born as one) and the Chinese leaders. His short story "The Cure" is in the same vein, detailing how a local government representative-probably self-appointed during the Cultural Revolution, although that is never made quite clear in the story-leads a lynching of the village’s two most prominent leaders and their wives. But, as in most Mo Yan stories, the bitterness directed at the lyncher is double-edged with the bitter look at a local peasant who sees the deaths of the two village leaders as a desperate chance to possibly rescue his mother from impending blindness. The story is coldly realistic and totally chilling in the rational way it treats the series of events. Su Tong is the author of the novella "Raise The Red Lantern", the basis of the wonderful movie. His "The Brothers Shu" is a bitter look at some traditional character weaknesses of Chinese people, and particularly how they affect family life. The Shu family is incredibly dysfunctional. The father nightly climbs up the side of his two-family house to have sex with the woman upstairs until her husband bolts her windows shut. So the woman sneaks downstairs to have sex in the younger son’s bedroom while the son is tied to his bed, gagged and blindfolded. Meanwhile the elder son abuses the girl upstairs until she falls in love with him. When she becomes pregnant, they are both so shamed they form a suicide pact, tie themselves together and jump into a river, where the boy is rescued in time but the girl dies. The younger son so hates his older brother-somewhat deservedly considering the abuse heaped on him by the brother-that he pours gasoline through his bedroom and sets it ablaze. And so on, complete with beatings and torments worthy of the most dysfunctional American families. While not a particularly likeable cast of characters, the story is strong and thoughtful. Perhaps the most moving part about "First Person", by Shi Tiesheng is in the brief author description in the back of the book. Shi is described as “crippled during the Cultural Revolution”. So many lives were needlessly destroyed during that tumultuous decade, it is easy to feel that the arrest and subsequent conviction of the notorious Gang of Four was not nearly sufficient punishment for them. "First Person" tells the story of a man with a heart condition-Shi frequently writes about the lives of handicapped people, according to his description-who is visiting his new 21st floor apartment for the first time. While climbing the stairs very slowly, taking frequent rests, he notices a cemetery separated from the apartment building by a huge wall. On one side of the wall is sitting a woman, while on the other side stands a man. As the man climbs the stairs he fantasizes about why the couple are there, and why they are separated by the wall. Perhaps the man is having an affair, and the wife is spying on him as he rendezvous with his lover? But then the man notices a baby lying on a gravesite, being watched from a distance by the man, and he realizes that the couple is abandoning the child. An interesting story about the fanciful delusions a person can have, but with no real depth beyond that. Two stories involve fear of dentists in completely different ways. Wang Meng’s "A String of Choices" is a very funny story that combines a bitter look at both Eastern and Western medicine with perhaps the most extreme case of fear of dentists imaginable. Chen Ran’s "Sunshine Between the Lips" tells of a young girl whose adult male friend exposes himself to her. If that were not traumatic enough, after he is arrested for exposing himself to a complete stranger, he sets his apartment on fire and dies a brutal death. This event, combined with a near-fatal bout of meningitis, creates in the girl a deep fear of phallic objects such as needles and penises. So imagine her trauma when she develops impacted wisdom teeth at the same time as she gets married. While this description might sound a bit ludicrous, this story is very serious and very well-executed. A strong satire on how history can be rewritten to suit the writers’ needs is Li Xiao’s "Grass on the Rooftop". When a peasant’s hut goes on fire, he is rescued by a local student. The rescue is written up for an elementary school newspaper by a local child, but the story is picked up by other papers, changing radically with each reprinting until the rescuing student becomes a great hero of the Maoist revolution because of his supposed attempt to rescue a nonexistent portrait of Mao on the wall of the hut. While this story is uniquely Chinese in many ways, it resonates in all societies in which pride and agenda is often more important than the truth. Anybody interested in a look at contemporary Chinese society should enjoy this collection immensely |
||

|
Название книги: Chalice Авторы: Маккинли Робин Жанры: sf_fantasy Файл: fb2-182285-187147.zip/184659.fb2 Размер файла: 447,8 КБ Язык: Английский |
Читать онлайн |
| Скачать: | ||
| fb2 | ||
| fb2+zip | ||
| epub | ||
| mobi | ||
|
As the newly appointed Chalice, Mirasol is the most important member of the Master's Circle. It is her duty to bind the Circle, the land and its people together with their new Master. But the new Master of Willowlands is a Priest of Fire, only drawn back into the human world by the sudden death of his brother. No one knows if it is even possible for him to live amongst his people. Mirasol wants the Master to have his chance, but her only training is as a beekeeper. How can she help settle their demesne during these troubled times and bind it to a Priest of Fire, the touch of whose hand can burn human flesh to the bone? Robin McKinley weaves a captivating tale that reveals the healing power of duty and honor, love and honey |
||

|
Название книги: Chalice of Blood Авторы: Тримейн Питер Жанры: det_history Серии: Sister Fidelma No в серии:21 Файл: fb2-453300-458899.zip/458557.fb2 Размер файла: 661,7 КБ Язык: Английский |
Читать онлайн |
| Скачать: | ||
| fb2 | ||
| fb2+zip | ||
| epub | ||
| mobi | ||

|
Название книги: Challenge for the Pacific: Guadalcanal: The Turning Point of the War Авторы: Леки Роберт Жанры: nonf_military Файл: fb2-375000-381999.zip/380927.fb2 Размер файла: 1,7 МБ Язык: Английский |
Читать онлайн |
| Скачать: | ||
| fb2 | ||
| fb2+zip | ||
| epub | ||
| mobi | ||
|
From Robert Leckie, the World War II veteran and New York Times bestselling author of Helmet for My Pillow, whose experiences were featured in the HBO miniseries The Pacific, comes this vivid narrative of the astonishing six-month campaign for Guadalcanal. From the Japanese soldiers’ carefully calculated—and ultimately foiled—attempt to build a series of impregnable island forts on the ground to the tireless efforts of the Americans who struggled against a tenacious adversary and the temperature and terrain of the island itself, Robert Leckie captures the loneliness, the agony, and the heat of twenty-four-hour-a-day fighting on Guadalcanal. Combatants from both sides are brought to life: General Archer Vandegrift, who first assembled an amphibious strike force; Isoroku Yamamoto, the naval general whose innovative strategy was tested; the island-born Allied scout Jacob Vouza, who survived hideous torture to uncover the enemy’s plans; and Saburo Sakai, the ace flier who shot down American planes with astonishing ease. Propelling the Allies to eventual victory, Guadalcanal was truly the turning point of the war. Challenge for the Pacific is an unparalleled, authoritative account of this great fight that forever changed our world |
||

|
Название книги: Chambers of Death Авторы: Ройал Присцилла Жанры: det_history Серии: Medieval Mystery No в серии:6 Файл: fb2-449400-453299.zip/451968.fb2 Размер файла: 853,6 КБ Язык: Английский |
Читать онлайн |
| Скачать: | ||
| fb2 | ||
| fb2+zip | ||
| epub | ||
| mobi | ||

|
Название книги: Chameleon Авторы: Kienzle William X Жанры: det_crime Серии: Father Koesler No в серии:13 Файл: fb2-411000-415299.zip/413346.fb2 Размер файла: 1,4 МБ Язык: Английский |
Читать онлайн |
| Скачать: | ||
| fb2 | ||
| fb2+zip | ||
| epub | ||
| mobi | ||
|
Название книги: Chameleon Авторы: Макклюр Кен Жанры: thriller Файл: fb2-359000-364999.zip/363636.fb2 Размер файла: 605,9 КБ Язык: Английский |
Читать онлайн |
| Скачать: | ||
| fb2 | ||
| fb2+zip | ||
| epub | ||
| mobi | ||

|
Название книги: Chameleon People Авторы: Лалум Ханс Улав Жанры: detective Файл: fb2-605289-609999.zip/608912.fb2 Размер файла: 790,3 КБ Язык: Русский |
Читать онлайн |
| Скачать: | ||
| fb2 | ||
| fb2+zip | ||
| epub | ||
| mobi | ||
|
From the international bestselling author, Hans Olav Lahlum, comes Chameleon People, the fourth murder mystery in the K2 and Patricia series. 1972. On a cold March morning the weekend peace is broken when a frantic young cyclist rings on Inspector Kolbjorn 'K2' Kristiansen's doorbell, desperate to speak to the detective. Compelled to help, K2 lets the boy inside, only to discover that he is being pursued by K2's colleagues in the Oslo police. A bloody knife is quickly found in the young man's pocket: a knife that matches the stab wounds of a politician murdered just a few streets away. The evidence seems clear-cut, and the arrest couldn't be easier. But with the suspect's identity unknown, and the boy refusing to speak, K2 finds himself far from closing the case. And then there is the question that K2 can't get out of his head: why would a guilty man travel directly to a police detective from the scene of his own brutal crime? |
||

|
Название книги: Champagne for One Авторы: Стаут Рекс Жанры: det_classic Серии: Nero Wolfe No в серии:51 Файл: fb2-074392-091839.zip/75659.fb2 Размер файла: 387,7 КБ Язык: Английский |
Читать онлайн |
| Скачать: | ||
| fb2 | ||
| fb2+zip | ||
| epub | ||
| mobi | ||
|
Faith Usher tells anyone willing to listen that she wants to kill herself. So when she dies after drinking champagne at the annual gala for unwed mothers, everyone insists that it was suicide. Everyone except Archie Goodwin, the perennial wise guy, who was watching her drink |
||

|
Название книги: Champagne pour tout le monde ! Авторы: Дар Фредерик Жанры: det_espionage, det_irony Серии: Le Commissaire San-Antonio No в серии:107 Файл: fb2-561000-564999.zip/562719.fb2 Размер файла: 711,9 КБ Язык: Французский |
Читать онлайн |
| Скачать: | ||
| fb2 | ||
| fb2+zip | ||
| epub | ||
| mobi | ||
|
Je vais te dire… Moi, quand je prête mon aimable concours à une gourgandine pour l'aider à perpétrer un vol et que ma carrière de flic d'élite ne sombre pas dans l'aventure. Quand les bombes m'éclatent sous les claouis sans me causer la moindre égratignure. Quand je suis expédié à perpète au fond d'un puits, d'où personne n'est jamais sorti, pas même la vérité, et que j'en remonte frais comme un gardon. Oui, moi, quand tout ça, plus le reste m'arrive, à la fin de ces délicatesses je respire un grand coup et je m'écrie : — Champagne pour tout le monde ! A la bonne mienne, les gars ! |
||

|
Название книги: Champagne Tastes on a Crystal Budget Авторы: Rosen Gary Жанры: home_sex Файл: fb2-193823-199572.zip/194539.fb2 Размер файла: 39,0 КБ Язык: Английский |
Читать онлайн |
| Скачать: | ||
| fb2 | ||
| fb2+zip | ||
| epub | ||
| mobi | ||

|
Название книги: Champions Of The Gods Авторы: Грин Роланд Джеймс, Лорд Джеффри Жанры: sf_heroic Серии: Richard Blade No в серии:21 Файл: fb2-212752-216641.zip/214530.fb2 Размер файла: 425,4 КБ Язык: Английский |
Читать онлайн |
| Скачать: | ||
| fb2 | ||
| fb2+zip | ||
| epub | ||
| mobi | ||

|
Название книги: Chance Авторы: Конрад Джозеф Жанры: prose_classic Файл: fb2-689300-691099.zip/690650.fb2 Размер файла: 826,5 КБ Язык: Английский |
Читать онлайн |
| Скачать: | ||
| fb2 | ||
| fb2+zip | ||
| epub | ||
| mobi | ||
|
Chance is narrated by Conrad’s regular narrator, Charles Marlow, but is characterised by a complex, nested narrative in which different narrators take up the story at different points and attempt to interpret various episodes in the life of Miss de Barral, the daughter of a convicted swindler named Smith de Barral (though this character is famous in the world of the novel as a criminal, he may, at least at first, have been merely an incompetent banker). Miss de Barral leads a sheltered life while her father is prosperous, then must rely on the generosity of others, who resent her or have agendas for her, before she escapes by marrying one Captain Anthony. Much of the book involves the musing of the various narrators over what she and the Captain expected from this union, and what they actually got from it. When her father is released from prison, he joins them on ship, and the book heads towards its denouement (source: Wikipedia) |
||

|
Название книги: Chance Авторы: Нанн Кем Жанры: thriller Файл: fb2-599000-602999.zip/600648.fb2 Размер файла: 668,4 КБ Язык: Английский |
Читать онлайн |
| Скачать: | ||
| fb2 | ||
| fb2+zip | ||
| epub | ||
| mobi | ||
|
In an intense tale of psychological suspense, a San Francisco psychiatrist becomes sexually involved with a female patient who suffers from multiple personality disorder, and whose pathological ex-husband is an Oakland homicide detective |
||

|
Название книги: Chance Авторы: Уиллис Конни Жанры: sf Файл: fb2-558000-560999.zip/558960.fb2 Размер файла: 113,3 КБ Язык: Английский |
Читать онлайн |
| Скачать: | ||
| fb2 | ||
| fb2+zip | ||
| epub | ||
| mobi | ||

|
Название книги: Chance Encounter Авторы: Шелвис Джилл Жанры: love_contemporary Серии: Men of Chance No в серии:3 Файл: fb2-375000-381999.zip/380181.fb2 Размер файла: 352,6 КБ Язык: Английский |
Читать онлайн |
| Скачать: | ||
| fb2 | ||
| fb2+zip | ||
| epub | ||
| mobi | ||
|
T. J. Chance is a wild, uninhibited adventurer. Ally Wheeler is one scared little mouse. But she's determined to change all that, and T.J. is her ticket to a brand-new life. If she can hold her own with this sexy rebel, she can do anything! No way is Chance going to be responsible for some city girl who wants to dog his heels and have "adventures." Of course, if she's looking for a wild time, he can certainly deliver. And the longer Ally stays in Wyoming, the harder it's going to be for him not to do the wild thing with her… |
||

|
Название книги: Chanel No.5. История создателя легенды Авторы: Бо Натали Жанры: nonf_biography Файл: fb2-771735-773746.zip/771979.fb2 Размер файла: 3,6 МБ Язык: Русский |
Читать онлайн |
| Скачать: | ||
| fb2 | ||
| fb2+zip | ||
| epub | ||
| mobi | ||
|
Эрнест Бо один из самых выдающихся талантов французской парфюмерии. Выходец из Русской империи французского происхождения, он совершил революцию в мире парфюма. Создатель Chanel No.5 не только создал легенду в мире ароматов, но и прошел непростой жизненный путь. На его веку две войны, революция в России и эмиграция во Францию. Через что пришлось пройти парфюмеру? Как Эрнест Бо познакомился с Коко Шанель? Как сложилась личная жизнь талантливого мастера парфюмерного дела? Что вдохновило его на создание аромата и как это связано с Россией? В своем главном детище, Chanel No.5, он запечатлел незабываемый аромат северной природы, оставив след не только в истории парфюмерии, но и создав один из символов мировой культуры |
||

|
Название книги: Change of Command Авторы: Мун Элизабет Зухер Жанры: sf_action, sf_space Серии: Serrano Legacy No в серии:6 Файл: fb2-582000-585999.zip/585538.fb2 Размер файла: 783,4 КБ Язык: Английский |
Читать онлайн |
| Скачать: | ||
| fb2 | ||
| fb2+zip | ||
| epub | ||
| mobi | ||
|
Rejuvenants fear the backlash caused by bad drugs; they want to ensure that nothing interferes with their pursuit of long life—or the profit that comes from promising it to others. Neighbor states fear the aggressive expansion of the Familias Regnant, fuelled by population growth and extended lifespan. Within the Regular Space Service, those who have received experimental rejuvenations fear they may have been given bad drugs on purpose. Esmay Suiza’s family fears that her marriage to an offworlder will damage their position. Barin Serrano’s family fears that his marriage to a Landbride of Altiplano will damage his career and their reputation. Fear begets violent reactions—from foreign governments, from great Families determined to maintain or increase their power, from internal rivalries in the Fleet—and nothing escapes the resultant bloodbath unscathed. As Esmay and Barin struggle to reconcile their families, others have more cosmic struggles to win |
||

|
Название книги: Change of heart Авторы: Пиколт Джоди Линн Жанры: prose_contemporary Файл: fb2-153556-158325.zip/155182.fb2 Размер файла: 727,5 КБ Язык: Английский |
Читать онлайн |
| Скачать: | ||
| fb2 | ||
| fb2+zip | ||
| epub | ||
| mobi | ||

|
Название книги: Change-up: Mystery at the World Series Авторы: Файнштейн Джон Жанры: detective Серии: Final Four Mystery No в серии:4 Файл: fb2-175952-182284.zip/181025.fb2 Размер файла: 483,5 КБ Язык: Английский |
Читать онлайн |
| Скачать: | ||
| fb2 | ||
| fb2+zip | ||
| epub | ||
| mobi | ||
|
A behind-the-scenes mystery at the World Series from bestseller John Feinstein. Bestselling author, journalist, and Edgar Award winner John Feinstein is back with another high-stakes sports mystery. Teen reporters Stevie Thomas and Susan Carol Anderson are covering baseball's World Series, and during the course of an interview with a new hot pitcher, they discover more than a few contradictions in his life story. What's he hiding? An embarrassing secret? A possible crime? Let the investigation begin! |
||

|
Название книги: Changed Авторы: Хантер Эйлин Жанры: love_erotica, love_sf Серии: The Wolf's Den No в серии:2 Файл: fb2-472000-475999.zip/472107.fb2 Размер файла: 453,6 КБ Язык: Английский |
Читать онлайн |
| Скачать: | ||
| fb2 | ||
| fb2+zip | ||
| epub | ||
| mobi | ||
|
Beta werewolf Declan Schroder knows Rachel Gentry is his mate. The hard-as-nails female is more than he could ask for—intense, clever and sexy as sin. There’s only one problem. Rachel is human and fears his kind. She’s receptive to his advances—their sexual chemistry is impossible to deny—until an attack by a rogue werewolf threatens to destroy their newfound bond. As Declan’s mating heat rises, he knows he’ll do whatever it takes to claim Rachel as his own. To keep her he’ll have to love her from dusk to dawn, introducing her to pleasures she’s never known. Loving a big, bad wolf is wicked and dangerous, but not in the way she’s bound to regret |
||

|
Название книги: Changeless Авторы: Кэрригер Гейл Жанры: sf_fantasy_city Серии: Parasol Protectorate No в серии:2 Файл: fb2-300000-308999.zip/302599.fb2 Размер файла: 611,2 КБ Язык: Английский |
Читать онлайн |
| Скачать: | ||
| fb2 | ||
| fb2+zip | ||
| epub | ||
| mobi | ||
|
Alexia Tarabotti, the Lady Woolsey, awakens in the wee hours of the mid-afternoon to find her husband, who should be decently asleep like any normal werewolf, yelling at the top of his lungs. Then he disappears — leaving her to deal with a regiment of supernatural soldiers encamped on her doorstep, a plethora of exorcised ghosts, and an angry Queen Victoria. But Alexia is armed with her trusty parasol, the latest fashions, and an arsenal of biting civility. Even when her investigations take her to Scotland, the backwater of ugly waistcoats, she is prepared: upending werewolf pack dynamics as only the soulless can. She might even find time to track down her wayward husband, if she feels like it |
||

|
Название книги: Changeling Авторы: Нортон Андрэ Жанры: sf_fantasy Серии: Witch World No в серии:0 Файл: fb2-558000-560999.zip/559110.fb2 Размер файла: 145,5 КБ Язык: Английский |
Читать онлайн |
| Скачать: | ||
| fb2 | ||
| fb2+zip | ||
| epub | ||
| mobi | ||

|
Название книги: Changeling Авторы: Грегори Филиппа Жанры: sf_fantasy Серии: Order of Darkness No в серии:1 Файл: fb2-449400-453299.zip/450207.fb2 Размер файла: 1,3 МБ Язык: Английский |
Читать онлайн |
| Скачать: | ||
| fb2 | ||
| fb2+zip | ||
| epub | ||
| mobi | ||

|
Название книги: Changeling Авторы: Тирнан Кейт Жанры: sf_horror Серии: Sweep No в серии:8 Файл: fb2-168103-172702.zip/170300.fb2 Размер файла: 342,8 КБ Язык: Английский |
Читать онлайн |
| Скачать: | ||
| fb2 | ||
| fb2+zip | ||
| epub | ||
| mobi | ||
|
When Morgan receives a shocking revelation about her family, she's thrown into a moral tailspin, believing that her essential nature is evil. Is her dark heritage too powerful to overcome? |
||

|
Название книги: Changeling Авторы: Ли Стивен Жанры: sf Серии: Isaac Asimov`s Robot City, Robots and Aliens No в серии:1, 1 Файл: fb2-104215-113436.zip/112166.fb2 Размер файла: 541,4 КБ Язык: Английский |
Читать онлайн |
| Скачать: | ||
| fb2 | ||
| fb2+zip | ||
| epub | ||
| mobi | ||

|
Название книги: Changeling Авторы: Желязны Роджер Жанры: sf Серии: Wizard World No в серии:1 Файл: fb2-104215-113436.zip/106091.fb2 Размер файла: 428,2 КБ Язык: Английский |
Читать онлайн |
| Скачать: | ||
| fb2 | ||
| fb2+zip | ||
| epub | ||
| mobi | ||

|
Название книги: Changer of Worlds Авторы: Флинт Эрик , Вебер Дэвид Жанры: sf_space Серии: Changer of Worlds No в серии:2 Файл: fb2-074392-091839.zip/75728.fb2 Размер файла: 820,3 КБ Язык: Английский |
Читать онлайн |
| Скачать: | ||
| fb2 | ||
| fb2+zip | ||
| epub | ||
| mobi | ||
|
Lady Dame Honor Harrington—starship captain, admiral, Steadholder, and Duchess—has spent decades defending the Star Kingdom of Manticore against all comers. Along the way, she has become the legend known as "the Salamander" from her habit of always being where the fire is hottest . . . and also a national bestseller (Ashes of Victory: #7, The Wall Street Journal). But it’s a big universe, and Honor’s actions affect a lot of lives, not all of them human. And their actions affect her —a lesson "Ms. Midshipwoman Harrington" learns years before rising to command rank when a desperate battle against "pirates" who aren’t quite what they seem begins her brilliant career. Closer to home, in "Changer of Worlds," a secret that the alien treecats have kept from their human friends for hundreds of years is about to come out . . . and completely change the relationship between the two species forever. Meanwhile, Eric Flint weighs in with "From the Highlands." Honor can’t be everywhere, so when the People’s Republic of Haven tries to stage a political assassination on Earth, Anton Zilwicki—husband of one of the Star Kingdom’s most revered military martyrs, and father of a young woman who is clearly a chip off the old block—steps into the breach . . . and takes the opportunity to settle some old scores along the way. And finally, Esther McQueen and Oscar Saint-Just square off for their final confrontation in Noveau Paris in "Nightfall." |
||

|
Название книги: Changer’s Moon Авторы: Клейтон Джоу Жанры: sf_fantasy Серии: Duel of Sorcery No в серии:3 Файл: fb2-216642-221999.zip/219426.fb2 Размер файла: 769,2 КБ Язык: Английский |
Читать онлайн |
| Скачать: | ||
| fb2 | ||
| fb2+zip | ||
| epub | ||
| mobi | ||

|
Название книги: Changes Авторы: Стил Даниэла Жанры: love_contemporary Файл: fb2-593000-596999.zip/594569.fb2 Размер файла: 905,9 КБ Язык: Английский |
Читать онлайн |
| Скачать: | ||
| fb2 | ||
| fb2+zip | ||
| epub | ||
| mobi | ||

|
Название книги: Changes Авторы: Лэки Мерседес Жанры: sf_fantasy Серии: 12. Collegium Chronicles No в серии:3 Файл: fb2-400000-405999.zip/402754.fb2 Размер файла: 726,2 КБ Язык: Английский |
Читать онлайн |
| Скачать: | ||
| fb2 | ||
| fb2+zip | ||
| epub | ||
| mobi | ||

|
Название книги: Changes Авторы: Батчер Джим Жанры: sf_detective, sf_fantasy_city Серии: Dresden Files No в серии:12 Файл: fb2-193823-199572.zip/194793.fb2 Размер файла: 892,4 КБ Язык: Английский |
Читать онлайн |
| Скачать: | ||
| fb2 | ||
| fb2+zip | ||
| epub | ||
| mobi | ||
|
Long ago, Susan Rodriguez was Harry Dresden's lover—until she was attacked by his enemies, leaving her torn between her own humanity and the bloodlust of the vampiric Red Court. Susan then disappeared to South America, where she could fight both her savage gift and those who cursed her with it. Now Arianna Ortega, Duchess of the Red Court, has discovered a secret Susan has long kept, and she plans to use it—against Harry. To prevail this time, he may have no choice but to embrace the raging fury of his own untapped dark power. Because Harry's not fighting to save the world... He's fighting to save his child |
||

|
Название книги: Changing Focus Авторы: Манн Марилу Жанры: sf_fantasy Серии: Lusting Wild No в серии:3 Файл: fb2-175952-182284.zip/179429.fb2 Размер файла: 401,5 КБ Язык: Английский |
Читать онлайн |
| Скачать: | ||
| fb2 | ||
| fb2+zip | ||
| epub | ||
| mobi | ||
|
Reluctant to be a Pack Alpha, Micah Keeps Vigil has no hesitation about what he wants in a mate. A strong, intelligent, passionate and, most importantly, shifter female. He’s found her in photojournalist Olivia. She’s come to Micah’s lodge to write about winter sports. Olivia isn’t expecting a gorgeous man who encourages her wilder nature with a sizzling erotic encounter in her room. Nor does she anticipate the amount of steam they generate in the sauna. With Micah’s hot body and Olivia’s innate sensuality they generate enough heat to melt the snow around the lodge. One problem-Olivia isn’t aware she’s a shifter. She believes her vivid dreams are just that-dreams-and that her blackouts can be controlled with medication. There’s no way she’s been running through the woods on four feet! Micah has to convince Olivia to accept herself-paws and all-or lose her forever |
||

|
Название книги: Changing My Mind: Occasional Essays Авторы: Смит Зэди Жанры: prose_contemporary Файл: fb2-175952-182284.zip/182114.fb2 Размер файла: 904,1 КБ Язык: Английский |
Читать онлайн |
| Скачать: | ||
| fb2 | ||
| fb2+zip | ||
| epub | ||
| mobi | ||
|
A non fiction book One of Zadie Smith's great gifts as a novelist is her openness: both to character and ideas in her stories, and to what a novel itself should be. That she's a novelist was clear as soon she broke through with White Teeth in her early twenties, but what kind she'll be (or will be next) seems open to change. Which all, along with her consistent intelligence, grace, and wit, makes her an ideal essayist too, especially for the sort of "occasional essays" collected for the first time in Changing My Mind. She can make the case equally for the cozy "middle way" of E.M. Forster and the most purposefully demanding of David Foster Wallace's stories, both as a reader and, you imagine, as a writer who is considering their methods for her own. The occasions in this book didn't only bring her to write about writers, though: she also investigates, among other subjects, Katherine Hepburn, Liberia, and Barack Obama (through the lens of Pygmalion), and, in the collection's finest piece, recalls her late father and their shared comedy snobbery. One wishes more occasions upon her |
||

|
Название книги: Changing partners Авторы: Эротика и секс Автор неизвестен -- Жанры: love_erotica Серии: prudie pockets No в серии:11 Файл: fb2-262000-274999.zip/272106.fb2 Размер файла: 240,4 КБ Язык: Английский |
Читать онлайн |
| Скачать: | ||
| fb2 | ||
| fb2+zip | ||
| epub | ||
| mobi | ||